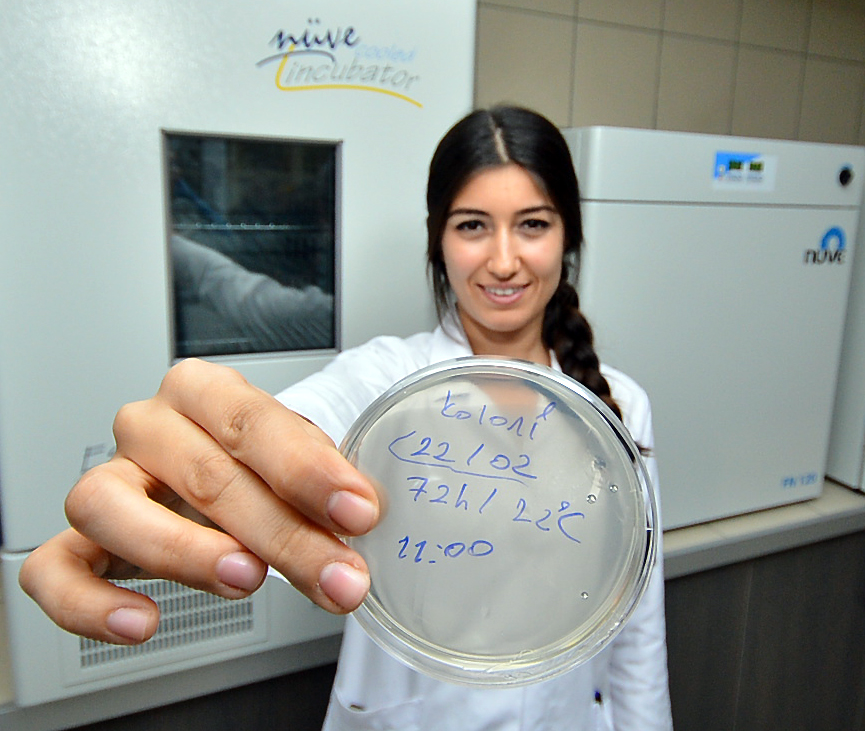

Yönetmelik gereği su satış istasyonlarını 31 Mart tarihinden itibaren kapatmak zorunda olan İzmir Büyükşehir Belediyesi, 7.6 milyon liralık yatırım yaparak Bornova Homeros Vadisi’nden gelen mineralli ve lezzetli kaynak sularını şişeleyecek bir tesis kurdu.
Çiğli’deki Kent Ekmek Fabrikası’nda dar gelirli vatandaşlara yönelik sağlıklı, besleyici ve ekonomik ekmek üretimi gerçekleştiren İzmir Büyükşehir Belediyesi, şimdi de İzmirliler’in evlerine uygun fiyatla kaliteli, sağlıklı ve lezzetli kaynak suyu ulaştıracak.